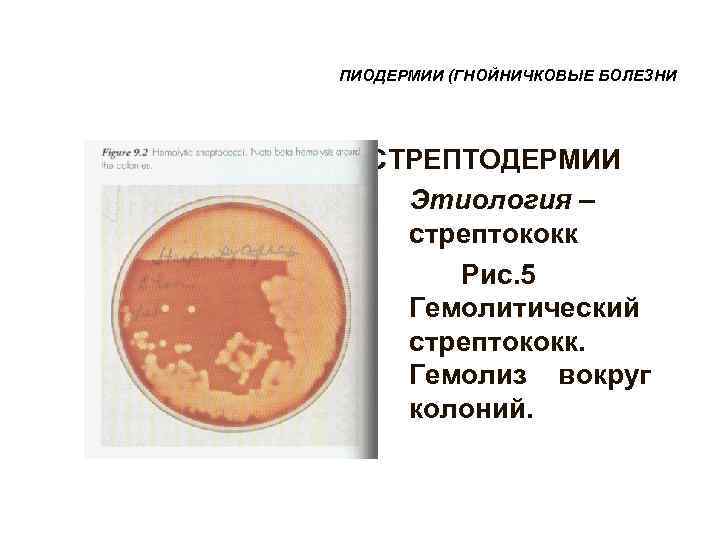
ПИОДЕРМИИ (ГНОЙНИЧКОВЫЕ БОЛЕЗНИ  СТРЕПТОДЕРМИИ  • Этиология – стрептококк  Рис. 5 Гемолитический

ПИОДЕРМИИ Выполнил: интерн 6 -062 группы

Пиодермии.Иембергенов А.ppt
- Количество слайдов: 76
ПИОДЕРМИИ Выполнил: интерн 6 -062 группы Иембергенов А. Д. Проверила
Стафилококки • По данным С. В. Сидоренко (2003 г. ), ~ 40% людей являются постоянными носителями St. аureus, у которых он обнаруживается на слизистых оболочках крыльев носа, коже подмышечных впадин и промежности. • Оставшуюся часть популяции относят к транзиторным носителям. • St. аureus обладает способностью к адгезии к кожным покровам, инвазивностью в тканях, препятствует фагоцитозу и выживает внутри фагоцитов (незавершенный фагоцитоз). • Эпидермальные стафилококки колонизируют практически весь кожный покров человека, они лишены факторов вирулентности, кроме способности к адгезии. С. А. Масюкова, В. В. Гладько, М. В. Устинов, 2007
• гемолитический (Str. hemolyticus), Стрептококки патогенный, относится к группе облигатных паразитов человека; • зеленящий (Str. viridans); • негемолитический. Стрептококки обладают выраженной антигенной активностью. По антигенным различиям полисахаридов разделены на 20 групп (от A до V): • А – возбудители ангин, тонзиллита, скарлатины, сепсиса, раневых инфекций кожи и других тканей, гломерулонефрита, ревматизма, рожистого воспаления; • В – возбудители мастита, урогенитальной инфекции у женщин, сепсиса, менингита; • C, G, H, F – обнаруживаются на слизистой оболочке зева при респираторных заболеваниях; • D – возбудители энтероколитов и подострого бактериального эндокардита. Стрептококки других групп редко обнаруживаются у человека, патогенны для животных. С. А. Масюкова, В. В. Гладько, М. В. Устинов, 2007
Факторы защиты кожи от бактериальных инфекций 1. Роговой слой обладает высокой плотностью и прочностью. Кератин этого слоя является химически неактивным веществом, а ороговевшие клетки могут быть расплавлены только в концентрированных кислотах и основаниях. 2. Постоянно происходит отшелушивание верхних слоев эпидермиса и механическое удаление м/о. Новосёлов В. С. , Плиева Л. Р. Пиодермии. /Российский медицинский журнал. – 2004 г. - № 5
Факторы защиты кожи от бактериальных инфекций 3. Кожа и бактериальная клетка имеют положительный электрический заряд, что способствует удалению микроорганизмов с поверхности эпидермиса. 4. На рост и размножение пиококков неблагоприятно влияет высокая концентрация ионов Н+ (р. Н 3, 5– 6, 7), бактерицидные, бактериостатические свойства тканевой жидкости и секретa потовых, сальных желез. Биохимический состав и количество секрета регулируются ЦНС и ВНС, эндокринными железами. Новосёлов В. С. , Плиева Л. Р. Пиодермии. /Российский медицинский журнал. – 2004 г. - № 5
Патогенез пиодермий 1. Экзогенные факторы: • загрязнение кожи при плохом уходе, • нарушение целостности кожного покрова, • переохлаждение и перегревание, • состояние окружающей среды, • облучение рентгеновскими лучами, • лечение ГКС и иммуно- депрессивными препаратами
Патогенез пиодермий 2. Эндогенные факторы: • заболевания эндокринной системы (сахарный диабет, недостаточность гипофизарно-надпочечниковой системы, щитовидной, половых желез); • генетическая предрасположенность; • изменение р. Н кожи в щелочную сторону, ↓бактерицидных свойств пота и секрета сальных желез; • заболевания ЦНС и ВНС; • гиповитаминозы, особенно А и С; • неполноценное питание, дисбактериоз; • истощающие организм заболевания, особенно кишечные интоксикации; • иммунодефицитные состояния. С. А. Масюкова, В. В. , Гладько, М. В. Устинов, 2007
ПИОДЕРМИИ (ГНОЙНИЧКОВЫЕ БОЛЕЗНИ) • Классификация пиодермитов (по этиологическому признаку и глубине залегания): • 1. Стафилококковые • - поверхностные (остиофолликулит, сикоз) • - глубокие (фурункул, гидраденит) • 2. Стрептококковые • - поверхностные (стрептококковое импетиго) • - глубокие (эктима) • 3. Смешанные • -поверхностное стрептостафилококковое импетиго • -смешанные хронические пиодермиты (пиогенная гранулема, шанкриформная пиодермия, хроническая язвенная пиодермия).
ПИОДЕРМИИ (ГНОЙНИЧКОВЫЕ БОЛЕЗНИ) • Этиология стафилодермий – стафилококк. Рис. 1 Колонии Staphylococcus aureus на кровяном агаре
ПИОДЕРМИИ (ГНОЙНИЧКОВЫЕ БОЛЕЗНИ) Рис. 2 Грам-позитивные Staphylococcus aureus через 24 часа после посева, микроскопия
ПИОДЕРМИИ (ГНОЙНИЧКОВЫЕ БОЛЕЗНИ) Рис. 3 Мазок (Грам- положительные кокки)
ПИОДЕРМИИ (ГНОЙНИЧКОВЫЕ БОЛЕЗНИ • Стафилодермия
ПИОДЕРМИИ (ГНОЙНИЧКОВЫЕ БОЛЕЗНИ • Фолликулит, вызванный • Staphylococcus aureus
Остиофолликулит возникает под влиянием механических и химических раздражений. В устье волосяного фолликула формируются пустулы, величиной от булавочной головки до просяного зерна, в центре пронизанной волосом и окаймленной венчиком гиперемии
Через 2– 4 дня пустула ссыхается в корочку, которая отпадает, не оставляя следа. Остиофолликулит
Остиофолликулиты могут быть как одиночными, так и множественными. Остиофолликулиты
Локализация разнообразная, но чаще всего наблюдается на коже задней поверхности шеи, предплечий, бедер и голеней. Поверхностный фолликулит Остиофолликулит
Угревая болезнь Фолликулиты (поверхностные и глубокие)
Фолликулиты
Фолликулиты
Фолликулиты
ПИОДЕРМИИ (ГНОЙНИЧКОВЫЕ БОЛЕЗНИ • сикоз
Сикоз наблюдается почти исключительно у мужчин. Начинается заболевание с появления фолликуляр-ных пустул, подобных остиофолликулитам. Постепенно вокруг пораженных фолли-кулов развивается Вульгарный сикоз реактивное воспаление с образованием разлитого дермального инфильтрата
На поверхности очага формируются гнойные корки. Эпилированные из пораженных фолликулов волосы окружены в корневой части толстой стекловидной муфтой. В результате высыпания новых пустул вокруг очага поражения последний медленно разрастается по периферии.
Вульгарный сикоз
ПИОДЕРМИИ (ГНОЙНИЧКОВЫЕ БОЛЕЗНИ) • Дифференциально-диагностические критерии сикоза • Сикоз Инфильтративно- • нагноительная трихофития Локализация подбородок, усы, вол. часть головы, шея, вол. часть головы • лобок Первичные гнойнички, элементы остиофолликулиты гнойнички Склонность к группировке есть нет Зуд нет Симптом «медовых сот» отрицательный положительный
ПИОДЕРМИИ (ГНОЙНИЧКОВЫЕ БОЛЕЗНИ • фурункул
Формирование узла сопровождается усилением болевых ощущений. Через несколько дней плотность узла уменьшается, Фурункул он размягчается в централь-ной части конуса, узел вскрывается с выделением гноя.
• При вскрытии узла обнаруживается омертвевшая ткань зеленоватого цвета, так называемый некротический стержень. Субъективные и объективные явления, как правило, после удаления стержня быстро исчезают.
• После отторжения некротического стержня, остается глубокая язва, которая заполняется грануляциями. • Язва заживает путем рубцевания.
• Иногда происходит увеличение размера фурункула за счет чрезмерного скопления гноя. • В этом случае некротический стержень подвергается почти полному расплавлению, и фурункул превращается в абсцесс – это так называемый абсцедирующий фурункул.
Фурункулез
ПИОДЕРМИИ (ГНОЙНИЧКОВЫЕ БОЛЕЗНИ • карбункул
Карбункул У истощенных и ослабленных больных возможно развитие сепсиса. Течение карбункула может усугубляется теми же осложнениями, которые развиваются при злокачественном фурункуле.
Карбункул
Карбункул
Карбункул
ПИОДЕРМИИ (ГНОЙНИЧКОВЫЕ БОЛЕЗНИ • гидраденит
В отличие от фурункула гнойно-некротический стержень не образуется. Постепенно язва очищается от гнойного содержимого, а после ее заживления остается небольшой втянутый рубец. Гидраденит
Гидраденит В ряде случаев гидраденит разрешается без вскрытия, однако после заживления образуется плотный, спаянный с тканями рубец.
Гидраденит Более часто и тяжело протекает гидраденит в области подмышечных впадин, где особенно легко наступает обсеменение стафилококками окружающей кожи и появляются свежие очаги поражения.
ПИОДЕРМИИ (ГНОЙНИЧКОВЫЕ БОЛЕЗНИ СТРЕПТОДЕРМИИ • Этиология – стрептококк Рис. 4 Стрептокки группы А. Цепи из грам- положительных коков
ПИОДЕРМИИ (ГНОЙНИЧКОВЫЕ БОЛЕЗНИ СТРЕПТОДЕРМИИ • Этиология – стрептококк Рис. 5 Гемолитический стрептококк. Гемолиз вокруг колоний.
ПИОДЕРМИИ (ГНОЙНИЧКОВЫЕ БОЛЕЗНИ СТРЕПТОДЕРМИИ • Этиология – стрептококк Рис. 6 Стрептококки в прямом мазке. Представлены кокки в цепях.
ПИОДЕРМИИ (ГНОЙНИЧКОВЫЕ БОЛЕЗНИ • Стрептококковое импетиго (фликтена)
Стрептококковое импетиго
Щелевидное импетиго
Вульгарное импетиго у ребенка 8 лет
Иногда пустула увеличивается до размеров крупной горошины (импетиго Бокхарта). Импетиго Бокхарта
ПИОДЕРМИИ (ГНОЙНИЧКОВЫЕ БОЛЕЗНИ) • ВУЛЬГАРНАЯ ЭКТИМА • Локализация – голени, будра, ягодицы, поясница • Эволюция элементов – пузырек, пустула, многослойная корочка золотисто-желтого цвета, язва, рубец • Дифференциальная диагностика – • - с фурункулом • -с сифилитической эктимой • - с коликвативным туберкулезом
ПИОДЕРМИИ (ГНОЙНИЧКОВЫЕ БОЛЕЗНИ • Вульгарная эктима
Эктимы
ПИОДЕРМИИ (ГНОЙНИЧКОВЫЕ БОЛЕЗНИ • заеда
ПИОДЕРМИИ (ГНОЙНИЧКОВЫЕ БОЛЕЗНИ • ИМПЕТИГО НОГТЕВЫХ ВАЛИКОВ (ПОВЕРХНОСТНЫЙ ПАНАРИЦИЙ, ТУРНИОЛЬ) • - фликтены на ногтевой фаланге пальцев кистей, подковообразно окружают ноготь, содержимое вначале серозное, затем мутно-гнойное, отечность, болезненность, иногда отторжение ногтевой кожицы (эпонихиума)
ПИОДЕРМИИ (ГНОЙНИЧКОВЫЕ БОЛЕЗНИ) ● СМЕШАННЫЕ СТРЕПТО-СТАФИЛОДЕРМИИ • -
ПИОДЕРМИИ (ГНОЙНИЧКОВЫЕ БОЛЕЗНИ • Вульгарное импетиго
Вульгарное импетиго (стрепто-стафилококковое) Фолликулиты Фликтены
Вульгарное импетиго (стрепто-стафилококковое)
Вульгарное импетиго
Стрепто-стафилококковая пиодермия
Вегетирующий гнойный стоматит
Язвенно- вегетирующая пиодермия у больной сахарным диабетом
ПИОДЕРМИИ (ГНОЙНИЧКОВЫЕ БОЛЕЗНИ • Шанкриформная пиодермия
Гангренозная пиодермия
Гангренозная пиодермия
Пиогенная гранулема
Шанкриформная пиодермия
ПИОДЕРМИИ (ГНОЙНИЧКОВЫЕ БОЛЕЗНИ) • ЛЕЧЕНИЕ ПИОДЕРМИЙ • - Этиологические средства • - Патогенетические средства с учетом индивидуальной реактивности, переносимости, чувствительности микрофлоры к назначаемым антибиотикам, а также с учетом глубины и распространенности процесса
ПИОДЕРМИИ (ГНОЙНИЧКОВЫЕ БОЛЕЗНИ) • В питании больных ограничиваются углеводы, исключаются соленые продукты, предпочтение отдается молочно-растительному режиму питания, пища также должна содержать достаточное количество белков, витаминов.
ПИОДЕРМИИ (ГНОЙНИЧКОВЫЕ БОЛЕЗНИ) • Антибиотики • - пенициллин и его полусинтетические аналоги (оспен, оспамокс, ампициллин, оксациллин) показаны детям вследствие малой токсичности, способности сохранять активность в кислой среде желудка, хорошей всасываемости • - тетрациклиновая группа ( с 8 лет), доксициклин • - макролиды (эритромицин, кларитромицин), азалиды (азитромицин) • Несмотря на обилие антибиотиков устойчивость микрофлоры возрастает.
ПИОДЕРМИИ (ГНОЙНИЧКОВЫЕ БОЛЕЗНИ) • Специфическая иммунотерапия • - стафилококковый анатоксин • - нативный и адсорбированный бактериофаг • - антистафилококковый гамма-глобулин • - стрептококковая вакцина • - бактериофаг стрептококковый • - антистафилококковая плазма
ПИОДЕРМИИ (ГНОЙНИЧКОВЫЕ БОЛЕЗНИ) • Общеукрепляющее лечение • - аутогемотерапия • - пиротерапия • - Витаминотерапия • - Ферментотерапия • - Физиотерапевтические методы воздействия (УФО, УВЧ, ультразвук, электрофорез, фонофорез, лазеротерапия)
НАРУЖНАЯ ТЕРАПИЯ • Наружная терапия • Антисептики: Красители, Нитрофураты, Кислоты • Масла, Альдегиды, Мупироцин • Красители: генциановый фиолетовый, бриллиантовый Красители зеленый, фуксин основной, этакридина лактат. Прим- ся при импетиго, остеофолликулитах и фолликулитов. • Нитрофураты: Фурациллин(в острый период стрептодермии). • Кислоты. При поверхностных формах пиодермии -2% водный раствор кислоты бензойной, кислота борная, 2% спиртовой раствор салициловой кислоты.
НАРУЖНАЯ ТЕРАПИЯ • Масла: Ихтиол. При фурункуле, гидрадените, глубоком фолликулите. • Альдегиды: Цитраль. При пиодермии у новорожденного в форме 0, 01% водноспиртового раствора цитраля, а также при маститах у кормящих женщин. • Мупироцин. Хорошая переносимость. Назначается в форме мази 2% мази 3 раза в день.
ПИОДЕРМИИ (ГНОЙНИЧКОВЫЕ БОЛЕЗНИ) • Наружное лечение • Проводится с учетом остроты, глубины, локализации, распространенности процесса, переносимости препаратов. • Поверхностные формы пиодермитов – дезинфицирующие средства, пузыри и пустулы вскрывают с последующей обработкой фукорцином, жидкостью Кастеллани, в складках – водные растворы этих препаратов, 1 -2% раствор перманганата калия, 1 -2% раствор резорцина, 1 -2 - 3% растворы хлорофиллипта. После туширования очагов антисептиками применяются дезинфицирующие пасты (паста Лассара, цинко-нафталанная), мази, содержащие антибиотики и кортикостероиды и аэрозоли. С целью предупреждения диссеминации процесса обрабатывают окружающую здоровую кожу 1 -2% салициловым спиртом в равных соотношениях с камфорным или настойкой календулы.
ПИОДЕРМИИ (ГНОЙНИЧКОВЫЕ БОЛЕЗНИ) • ПРОФИЛАКТИКА пиодермитов • - наблюдение беременных в женских консультациях (рациональный режим труда, отдыха, питания, соблюдение правил личной гигиены) • - профилактика стафилострептококковых инфекций в родильных домах, детских больницах, садах, школах • - периодические осмотры персонала, работающего с детьми • - среди взрослых: создание соответствующих санитарно- гигиенических условий на производстве, в сельском хозяйстве и в быту • - закаливание, спорт, рациональное питание, диспансеризация

